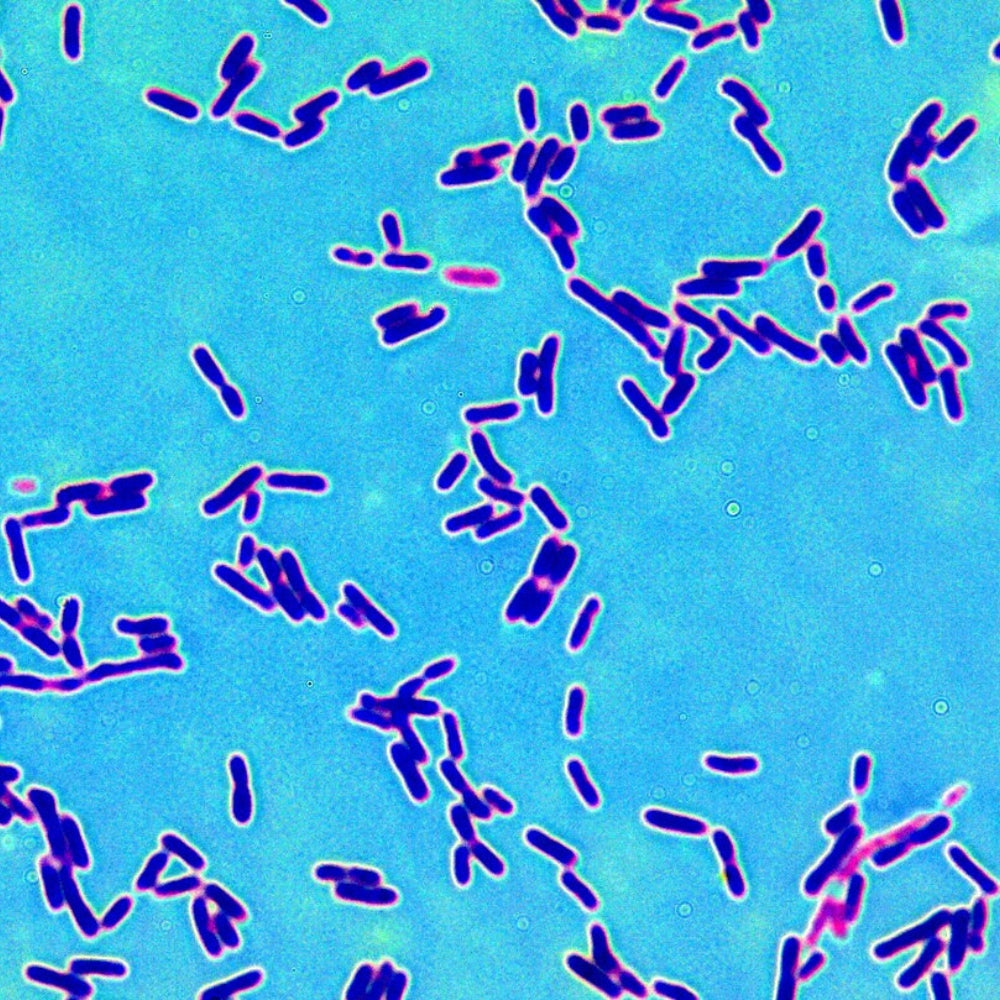
LiqVits_Stockphoto_Darmkulturen_Mikroskopansicht von Bakterien

Wie hängt alles zusammen?
Unsere Flora ist komplex und umfassend. Erst das aktive Zusammenspiel verschiedener Kulturen und Bestandteile sorgt für eine lebendige Flora.







Bakterienkulturen für Deinen Darm - Die nächste Generation unserer funktionalen Inhaltsstoffe
Hör auf Dein Bauchgefühl mit unserem Everyday PostMYotics. Die Milliarden von Zellkulturen sind eine innovative Ergänzung zu Probiotika oder alleine: Postbiotika sind unsere nächste Generation funktionaler Inhaltsstoffe.
Während es sich bei probiotischen Produkten um koloniebildende Mikroorganismen handelt, sind "Post-Produkte" Zellkulturen, welche aufgrund ihrer biologisch aktiven Bestandteile und Stoffwechselprodukte als Nahrung für Probiotika dienen.
PostMYotics können komplementär zu Probiotika verwendet werden und können einfach in Dein Getränk gemischt werden. In Deinem Darm befinden sich permanent rund 1.000 Billionen Darmkulturen. Unsere PostMYotics sind inspiriert von aktueller Mikrobiom-Forschung und bieten u.a. den Vorteil, dass wir sie in flüssiger Form, ready-to-use anbieten können.
✅ PostMYotics Hero mit 5 verschiedenen Bakterienstämmen
✅ Ca. 6 Mrd. Zellkulturen pro Portion
✅ Allein oder in der komplementär mit Probiotika
✅ Innovative OTD-Technologie zur Unterdrückung des Eigengeschmacks
✅ Extra Schutz dank innovativer Flasche
✅ Super Individuell Dosier- und Kombinierbar
✅ Schmeckt Immer so wie Du willst
Ohne Süßungsmittel, ohne Zuckerzusatz, ohne Geschmacks- oder Farbstoffe - nur was es wirklich braucht. Ultra Pure!
Empfehlung: 3x drücken = ca. 6 Mrd. Darmkulturen + Getränk Deiner Wahl, fertig! Dosiere frei nach Deinem Wunsch.
Flüssiges Nahrungsergänzungsmittel mit Zellkulturen und Vitaminen zur Zugabe in Getränken.
Inhalt: 150ml
Zutaten: Wasser, Lysat: Bifidobacterium animalis subsp. lactis, Lactobacillus acidophilus, Lacticaseibacillus paracasei, Lacticaseibacillus rhamnosus, Lactiplantibacillus plantarum; Pyridoxinhydrochlorid, D-Biotin, Säuerungsmittel: Zitronensäure; Verdickungsmittel: Xanthan; Konservierungsstoff: Kaliumsorbat, Natriumbenzoat
Kann Spuren von Soja enthalten.
| Nährwerte | Pro 100ml | Pro Portion (3ml) |
|---|---|---|
| Energie | 24 kJ / 6 kcal | 0,7 kJ / 0,2 kcal |
| Fett | 0 g | 0 g |
| davon gesättigte Fettsäuren | 0 g | 0 g |
| Kohlenhydrate | 1,4 g | 0,04 g |
| davon Zucker | 0,09 g | 0 g |
| Eiweiß | 0,02 g | 0 g |
| Salz | 0 g | 0 g |
| Nährstoffe | Menge pro Portion (3ml) | NRV* |
|---|---|---|
| Bifidobacterium lactis | 1,2x10⁹ ZK | ** |
| Lactobacillus acidophilus | 1,2x10⁹ ZK | ** |
| Lacticaseibacillus paracasei | 1,2x10⁹ ZK | ** |
| Lacticaseibacillus rhamnosu | 1,2x10⁹ ZK | ** |
| Lactiplantibacillus plantrum | 1,2x10⁹ ZK | ** |
| Vitamin B6 | 1,4 mg | 100% |
| Vitamin B7 (Biotin) | 50 µg | 100% |
*Referenzmengen (Nutrient Reference Value) nach EU-Verordnung 1169/2011 (LMIV)
**Keine Referenzmenge nach LMIV
ZK = Zellkulturen
LiqVits NICHT in heiße Getränke geben. Dies kann die Nährstoffe zerstören.
Die angegebene empfohlene tägliche Verzehrmenge sollte nicht überschritten werden.
Nahrungsergänzungsmittel sind kein Ersatz für eine ausgewogene, abwechslungsreiche Ernährung und gesunde Lebensweise.
Außerhalb der Reichweite von Kindern aufbewahren.
Kann bei übermäßige Verzehr abführend wirken.
Wenn Sie schwanger sind, stillen, Medikamente einnehmen, unter ärztlicher Beobachtung stehen, jünger als 18 Jahre sind oder an einer Erkrankung leiden, konsultieren Sie vor der Einnahme Ihren Arzt.
Mindesthaltbarkeitsdarum:

Auf der natürlichen Form der Vitamine & Nährstoffe.

Made in Germany mit Ärzten, Ökotrophologen und laborgeprüfter Formel.

Weniger CO2, Weniger Plastik: Außenmaterial der Flasche aus recyceltem Material.

Nach 100 Tagen nicht zufrieden? Du kriegst dein Geld zurück!

Zellkulturen aus 5 Strängen:
Bifidum lactis
Lactobacillus acidophilus
Lactobacillus paracasei
Lactobacillus rhamnosus
Lactobacillus plantrum

• Vitamin B6 trägt zu einem normalen Energiestoffwechsel bei
• Vitamin B6 trägt zu einer normalen Funktion des Immunsystems bei

• Biotin trägt zu einem normalen Energiestoffwechsel bei
• Biotin trägt zur Erhaltung normaler Schleimhäute bei

Unsere Flora ist komplex und umfassend. Erst das aktive Zusammenspiel verschiedener Kulturen und Bestandteile sorgt für eine lebendige Flora.
Mikrobiom
Milliarden Kulturen
Post vs. Pro
Ultra Clean

Postbiotika sind einer der entscheidenden Bestandteile für ein gutes Baugefühl. Doch was genau sind sie? Und wie verhalten sie sich mit anderen Biotika?
Am einfachsten ist es als kleine Metapher:
Stell dir deinen Darm als Garten vor. Während Präbiotika als "Dünger" die Grundlage legen, sind Probiotika als lebende Mikroorganismen die "neuen Pflanzen".
Aber damit deine "Pflanzen" gut wachsen und blühen benötigen sie Wasser und Nährstoffe.
Und genau das sind Postbiotika: Die "Giesskanne"!
Durch die biologisch aktiven Bestandteile und Stoffwechselprodukte unterstützen sie, dass der "Boden" kraftvoll und nährstoffreich ist und die "Pflanzen" ihr volles Potential erreichen können.
Nicht nur als Ergänzung.
Hunderte Billionen an Darmkulturen befinden sich bereits in deinem Darm. Die externe Zufuhr weiterer Bakterienkulturen kann sinnvoll sein, ist aber von Person zu Person unterschiedlich.
Postbiotika unterstützen auch die Funktionen jener Darmkulturen, welche bereits natürlich in deinem Darm sind.
Statt Milliarden weiterer "Pflanzen zu pflanzen", "gießt" du die vorhanden, damit diese "schöner wachsen" können.
Laktobakterien und Bifidobakterien zählen zu den wichtigsten Bakterien in unserem Darm. Umso breiter die Kombination von verschiedenen Arten im Darm befindlich sind, desto resistenter und lebendiger ist die Darmflora.
Unser Lysat setzt auf 5 verschiedene Bakterienstämmen, welche auf wissenschaftlichen Ergebnissen vom deutschen Marktführer in Deutschland entwickelt und kultiviert worden sind.
Dies sind:
Bifidum lactis
Lactobacillus acidophilus
Lactobacillus paracasei
Lactobacillus rhamnosus
Lactobacillus plantrum
Pro Push LiqVits befinden sich 2 Mrd Zellkulturen.
Einschlägige Expertenmeinungen empfehlen zwischen 1-10 Mrd Zellkulturen pro Portion - du kannst ganz individuell selbst entscheiden, wie viel dir gut hilft! Ob 2, 6 oder 10 Milliarden Immer ganz individuell und flexibel nach deinem optimalen Bedarf.

Nicht lebendige Zellkulturen können sich im Vergleich zu Lebendigen durch 4 wichtige Unterschiede auszeichnen:
1. Höhere Stabilität & Länger Haltbar
2. Besser Verträglich
3. Gezieltere Wirkung
4. Sicherer, da sie sich nicht wahllos vermehren können
Die Kombination aus beiden kann dabei optimal sein:
Die nicht lebenden Zellen aus Post-Produkten verstärken und unterstützen die positiven Eigenschaften von probiotischen Produkten.
Erste Studien legen diesen positiven Zusammenhang bereits nahe (vgl. Fachmagazin „Nutrients“).
So kann es für dich sowohl sinnvoll sein "nur" PostMYotics zu nutzen, aber auch sie aktiv mit probiotischen Produkten zu kombinieren.

Unsere Produkte reduzieren wir immer auf das absolut Nötigste. Kein Schnickschnack, keine Fake-Wirkstoffe. Du bekommst hochwirksame Inhaltsstoffe, ohne unnötige Zusätze:
Kein Zucker, Keine Süßungsmittel, Keine Farbstoffe, Keine Aromen.
Welche Zusätze du magst, welchen Geschmack du willst: Das solltest alles du selbst entscheiden. Nicht wir.
Wir geben dir die Benefits in laborgeprüften Formeln und aus 100% kontrollierter, deutscher Produktion. Alles andere weißt du besser.
Kein Shaken, Kein Umrühren, Keine Rückstände: Vermischt sich von allein perfekt im Glas.
DU entscheidest: Geschmack, Inhalt, Menge – kein „Marketing-Ass“, keine “Marktforschung“, kein "Business-Crack"
4x so Günstig wie Functional Drinks im Supermarkt - und LiqVits kann mehr!
Bye, Tablette. Bis zu 5x so hohe Absorption wie Tabletten, Kapseln & Co.
LiqVits sind eine absolut einzigartige Innovation. Wir verändern grundlegend wie Vitalstoffe schmecken können und funktionieren. Der direkte Vergleich mit veralteten Alternativen zeigt dies deutlich.
Wer gewinnt? Du!
Entwickelt & Produziert in Deutschland
Schmeckt Immer Wie du Willst
Leicht Individuell Dosierbar
Super Schnell & Einfach
Ultra Clean
Schmeckt Lecker?
Angenehme Einnahme?
Hoher Schutz der Nährstoffe?
Kein Zucker, Keine Kalorien?
Hohe Bioverfügbarkeit?

Entscheidest DU!
Tabletten & Co.
Drinks, Saft & Co.
Vitamin Gummies

Schluss mit Tablette & Co. Integriere dein neues Health-Ritual ganz einfach in deinen Lebensstil!
Du solltest es mindestens 3 Monate lang täglich nehmen.
Im Idealfall nimmst du es dauerhaft täglich, um positive Effekte beizubehalten.